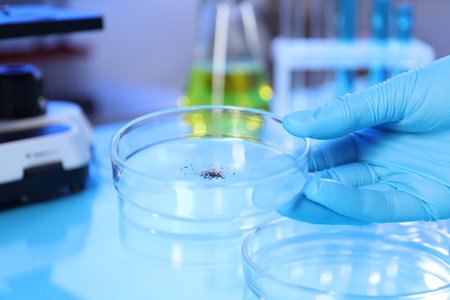
Scientist working with samples in Petri dishes at table in laboratory, closeupの写真素材

写真素材 - Scientist working with samples in Petri dishes at table in laboratory, closeup
作品情報
Scientist working with samples in Petri dishes at table in laboratory, closeup
- ID:248356004
- 作品種別:写真
- 作者名:liudmilachernetska
キーワード
- analysis
- analyzing
- background
- biochemistry
- biology
- biotechnology
- blue
- chemical
- chemistry
- closeup
- discovery
- dish
- dishes
- education
- equipment
- experiment
- female
- flask
- glassware
- gloves
- hand
- healthcare
- illness
- industry
- lab
- laboratory
- light
- liquid
- medicine
- microbiology
- person
- petri
- pharmaceutical
- pharmacology
- reagent
- research
- sample
- samples
- science
- scientific
- scientist
- studying
- supply
- table
- technology
- test
- tool
- woman
- work
- working
類似作品
A scientist in ...
Male Scientist ...
Blood test in t...
Scientist condu...
A focused scien...
Researchers wor...
Researchers wor...
A researcher in...
A focused male ...
scientist worki...
Blood test in t...
Blurred of red ...
Blood test in t...
A scientist exa...
Collaboration, ...
scientist worki...
A close-up shot...
A scientist in ...
Team Asian scie...
A scientist met...
Chemists in a l...
professional ch...
A scientist dre...
Scientist worki...
Lab assistant, ...
A laboratory te...
Researchers wor...
A dedicated sci...
A top-down view...
Biologist's exc...
Researchers wor...
A scientist in ...
A scientist in ...
Blood test in t...
Close-up of a m...
Female doctor h...
An engineer usi...
scientist worki...
A man wearing a...
Researcher usin...
Researchers wor...
An elderly scie...
Collaboration, ...
Collaboration, ...
Scientist condu...
Scientist condu...
scientist worki...
A researcher is...
professional ch...